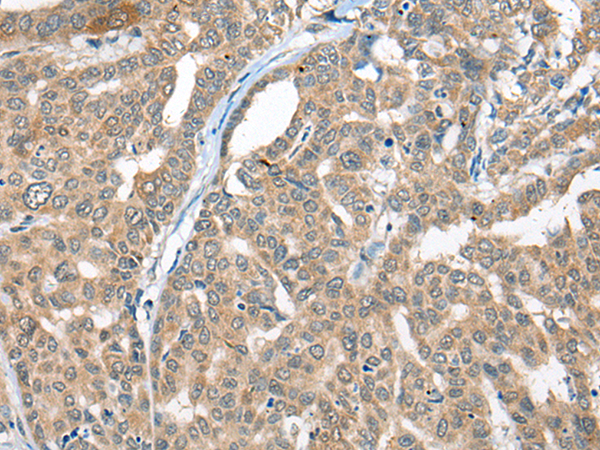

中文名稱:兔抗CBR3多克隆抗體
英文名稱: Anti-CBR3 rabbit polyclonal antibody
別 名: carbonyl reductase 3; hCBR3; SDR21C2; HEL-S-25
相關(guān)類別: 一抗
宿 主: Rabbit
標(biāo) 記 物: Unconjugate
克隆類型: rabbit polyclonal
技術(shù)規(guī)格
|
Background: |
Carbonyl reductase 3 catalyzes the reduction of a large number of biologically and pharmacologically active carbonyl compounds to their corresponding alcohols. The enzyme is classified as a monomeric NADPH-dependent oxidoreductase. CBR3 contains three exons spanning 11.2 kilobases and is closely linked to another carbonyl reductase gene - CBR1. |
|
Applications: |
ELISA, IHC |
|
Name of antibody: |
CBR3 |
|
Immunogen: |
Full length fusion protein |
|
Full name: |
carbonyl reductase 3 |
|
Synonyms: |
hCBR3; SDR21C2; HEL-S-25 |
|
SwissProt: |
O75828 |
|
ELISA Recommended dilution: |
5000-10000 |
|
IHC positive control: |
Human liver cancer and Human lung cancer |
|
IHC Recommend dilution: |
25-100 |

購(gòu)物車
購(gòu)物車 幫助
幫助
 021-54845833/15800441009
021-54845833/15800441009
